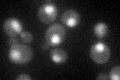
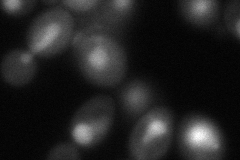
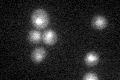

View description
Ubiquitin carboxyl-terminal hydrolase, ubiquitin-specific protease present in the nucleus and cytoplasm that cleaves ubiquitin from ubiquitinated proteins
Localization:
Intensity:
Fold change:
Significance:
-
C’ GFP library in SD
nucleus:cytosol38.54 -
N' NOP1pr-GFP in SD

nucleus119.164 -
N' TEF2pr-mCherry in SD

nucleus102.156 -
N' NATIVEpr-GFP in SD

nucleus26.1469 -
N' TEF2pr-VC and Cyto-VN in SD
nucleus76.3962 -
C’ GFP library in SD+DTT

punctate.nucleusN/AN/ANo -
C’ GFP library in SD+H2O2

nucleus.cytosol41.751.08No -
C’ GFP library in Starvation Media
nucleus,cytosol33.320.86No -
C’ GFP library on the background of Pup2-DaMP

nucleus:cytosol -
C’ GFP library on the background of CCT mutant

nucleus:cytosol41.75321.08303No
